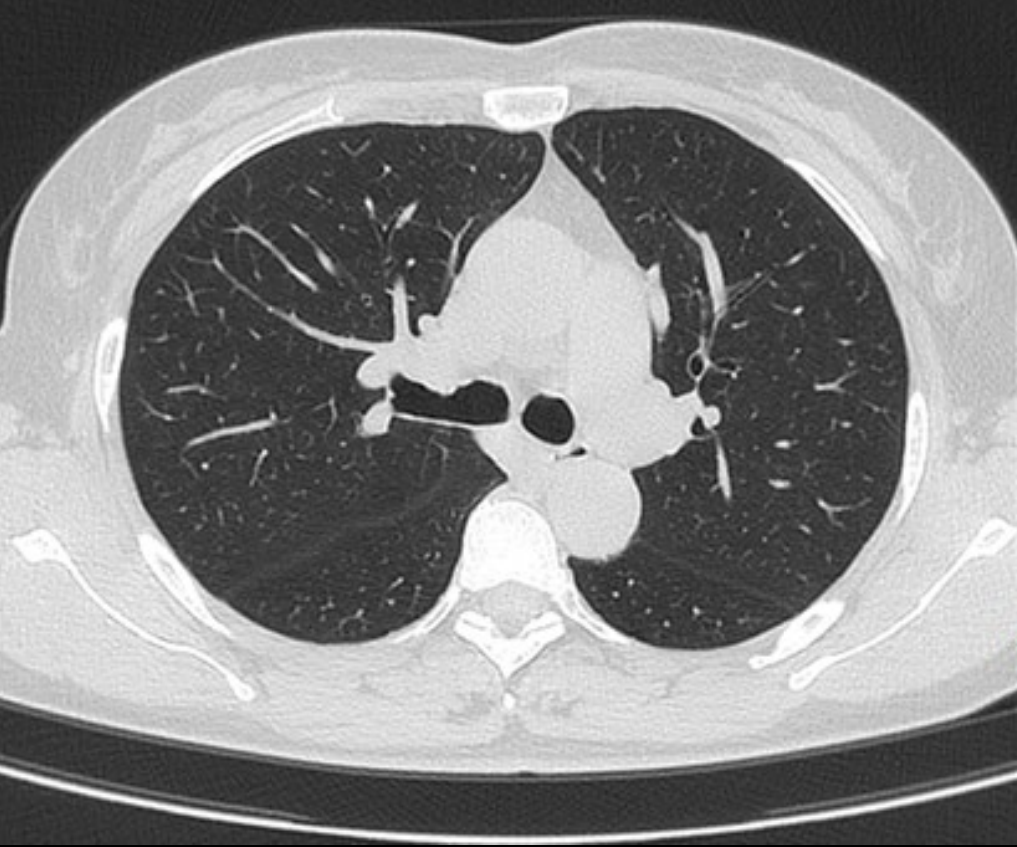

ANATOM C201 - CT Xoắn ốc 32 lát cắt
Bằng cách kết hợp bóng 3.5 MHU bền bỉ với detector 32 hàng độc đáo, hệ thống đạt hiệu suất sử dụng tia X vượt trội trong mỗi vòng quay. Năng lực lâm sàng toàn diện cùng quy trình vận hành chuẩn hóa bằng AI giúp nâng cao độ tin cậy chẩn đoán và chất lượng chăm sóc, trở thành giải pháp hấp dẫn cho mọi bệnh viện

Chỉ với 1 click tự động xác định chính xác phạm vi quét theo giao thức đã chọn, giảm thiểu điều chỉnh thủ công phức tạp

Chỉ với 1 click định vị chính xác iso-center, tối ưu hình ảnh và liều tia, giảm thiểu phơi nhiễm







Bộ thu Optiwave™ và protocols: giúp giảm hao tổn điện năng trong vận hành hàng ngày và nâng cao chất lượng hình ảnh

Hệ thống quản lý nhiệt hiệu quả, giảm thiểu phát sinh nhiệt và nhu cầu làm mát quá mức, nâng cao độ ổn định

Chế độ chờ thông minh giúp hệ thống luôn sẵn sàng tức thì, đồng thời tiết kiệm điện trong thời gian không hoạt động, giảm mức tiêu thụ năng lượng